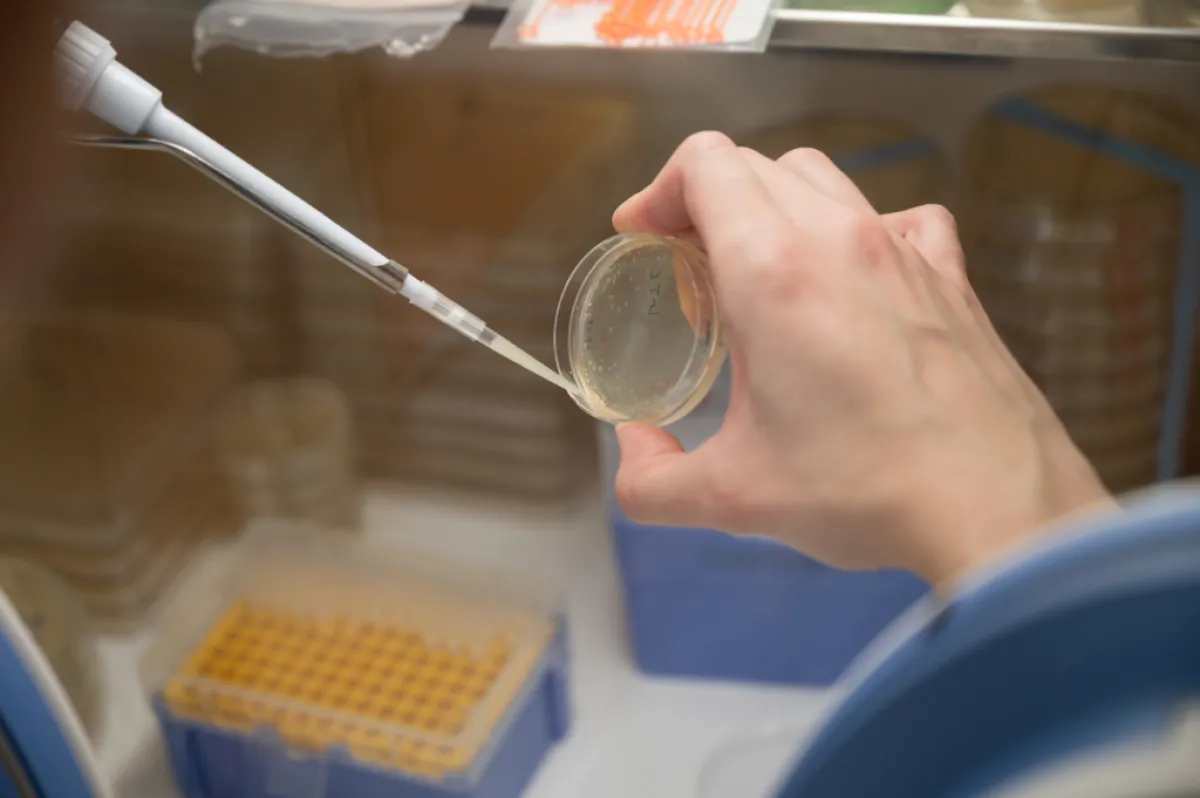
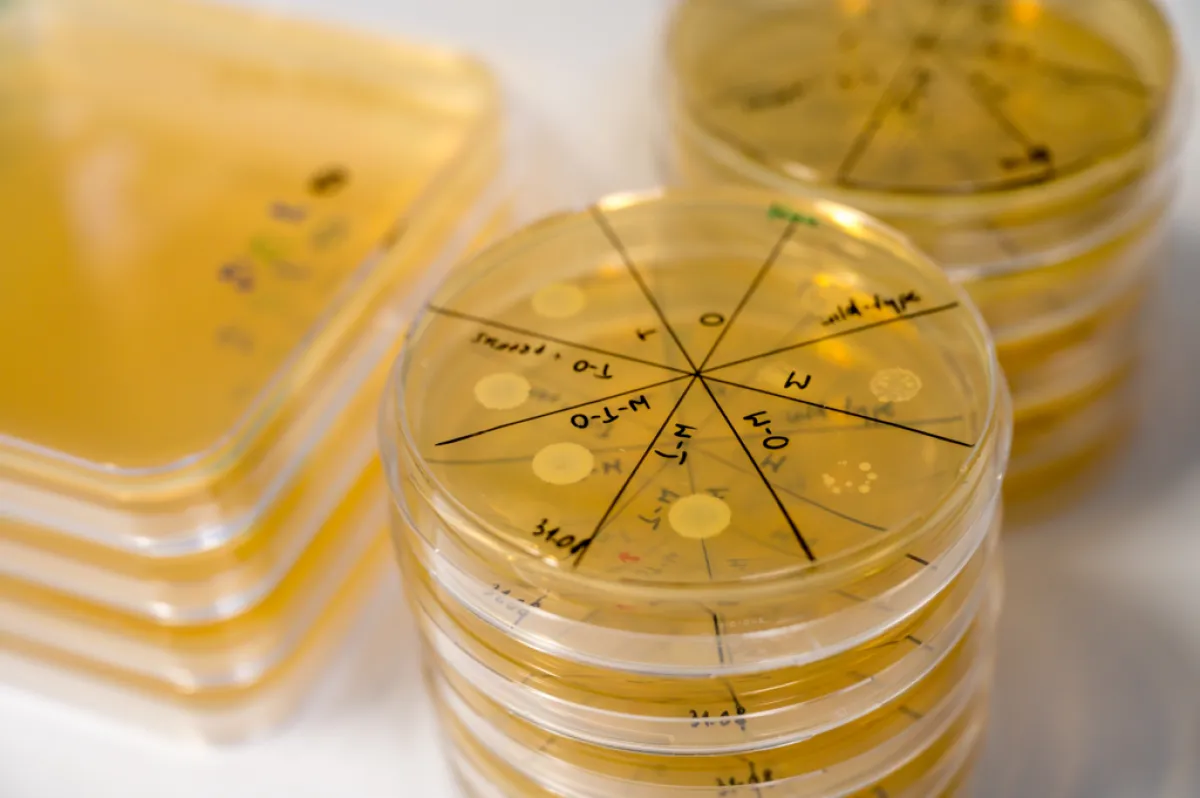

Simonetta Gribaldo À la recherche de la membrane perdue
Simonetta Gribaldo, Professeure à l’Institut Pasteur, Cheffe de l’équipe « Biologie Evolutive de la Cellule Microbienne » à l’Institut Pasteur, Paris
- 2023 • Impulscience

L'enveloppe cellulaire, souvent appelée membrane, constitue la principale interface entre un organisme et son environnement. Cette enveloppe est l'un des composants cellulaires les plus anciens et les plus essentiels. Avec son équipe à l’Institut Pasteur, Simonetta Gribaldo cherche à comprendre comment cette enveloppe a évolué chez les bactéries, une question fondamentale dans le domaine de la biologie évolutive et cellulaire.
L’enveloppe, un élément indispensable pour les bactéries
Chez les bactéries, l'enveloppe est impliquée dans un grand nombre de fonctions, comme le maintien de l'intégrité physique, l'absorption et la sécrétion de substances, la division et le mouvement de la cellule, et la communication entre les cellules. En fonction du type d'enveloppe qu’elles possèdent, les bactéries se regroupent en deux classes : les bactéries avec une membrane (dites à Gram-positif ou monodermes)- et celles avec deux membranes (dites à Gram-négatif ou didermes).
De nombreuses bactéries pathogènes connues (comme Escherichia, Pseudomonas, Helicobacter) sont didermes et leur membrane externe leur sert de barrière protectrice supplémentaire contre les agressions de l’environnement, dont les antibiotiques. Par conséquent, une meilleure compréhension des mécanismes impliqués dans la construction et le maintien de l'enveloppe des bactéries est un enjeu de recherche avec des applications importantes dans la lutte contre les maladies infectieuses.
L’ancêtre de toutes les bactéries était un diderme
Simonetta Gribaldo et son équipe à l’Institut Pasteur explorent la biodiversité des microorganismes en utilisant des approches qui permettent d’adresser des transitions évolutives majeures dans l’histoire de la vie. Leurs travaux récents ont défié un paradigme bien établi en évolution microbienne, en montrant que l'ancêtre de toutes les bactéries était un diderme, et que les monodermes ont évolué successivement par perte de la membrane externe. Il est intéressant de noter que toutes ces pertes se sont produites exclusivement dans une seule partie de l'arbre phylogénétique des bactéries, connue sous le nom de Terrabactéries, mais jamais dans les bactéries appartenant à la deuxième partie de cet arbre, les Gracilicutes.
Etant donné l’importance de la stabilité et de l'intégrité de l'enveloppe pour la vie des bactéries, les transitions d'un diderme à un monoderme ont dû être des événements critiques dans l'évolution des bactéries. Comment ces transitions se sont-elles produites ? Les Terrabactéries semblent être la clé pour répondre à cette question fondamentale en biologie évolutive.
Mais où est passée la deuxième membrane ?
La première action à entreprendre pour répondre à cette question sera de combler le manque d’information génétique sur les différents membres des Terrabactéries ainsi que d’obtenir des images de leurs enveloppes. Cela permettra de savoir quand et combien de fois la membrane externe a été perdue et d’identifier les gènes-clés qui ont été impliqués dans cette transition. L’effet des gènes identifiés sera testé expérimentalement chez Veillonella parvula, une Terrabactérie diderme qui se trouve dans le microbiote humain. Elle a été cultivée dans le laboratoire de Simonetta Gribaldo pour pouvoir être modifiée génétiquement et utilisée comme modèle pour cette étude.
Des mutants ainsi générés et dont la membrane externe sera fragilisée, seront forcés à la perdre dans des expériences « d’évolution accélérée » (des centaines de générations de bactéries). Ce sera la première fois que l’on génère un monoderme à partir d’un diderme dans un laboratoire !
Ainsi, ce projet soutenu par Impulscience® mettra en lumière l’une des principales transitions évolutives chez les bactéries, qui impacte non seulement leur biodiversité et leur évolution, mais également l'adaptation au stress et la perturbation de leur enveloppe. De plus, en identifiant le talon d’Achille qui permet aux bactéries de perdre leur membrane externe, ce projet pourra proposer des pistes dans la lutte contre les pathogènes.
Simonetta Gribaldo en quelques mots
Simonetta Gribaldo a effectué son doctorat à l’Université La Sapienza à Rome, en Italie. À la suite de ses séjours post-doctoraux dans plusieurs instituts de recherche parisiens, elle est recrutée à l’Institut Pasteur en 2005. Depuis, sa recherche est portée sur différentes facettes de la biodiversité et l’évolution des micro-organismes, comme les bactéries et les archées.
Simonetta Gribaldo est particulièrement attachée au mentorat des jeunes générations de chercheurs et chercheuses, dans le domaine de la bio-informatique et de la biologie de l’évolution.

Programme Impulscience
Impulscience attribue chaque année 7 nouveaux soutiens à des chercheuses et chercheurs en sciences de la vie. Concentré sur le milieu de carrière, ce programme a pour objectif de soutenir cette étape cruciale pour le développement des projets de recherche.
Tous les lauréats du prixAppel à candidatures
L'appel à candidatures est ouvert du 7 avril 2026 au 21 mai 2026 pour les candidats ayant répondu aux appels à projet ERC Starting et Consolidator 2025 ; et jusqu'au 22 juin 2026 pour les candidats ayant répondu à l'appel à projet ERC Advanced 2025.